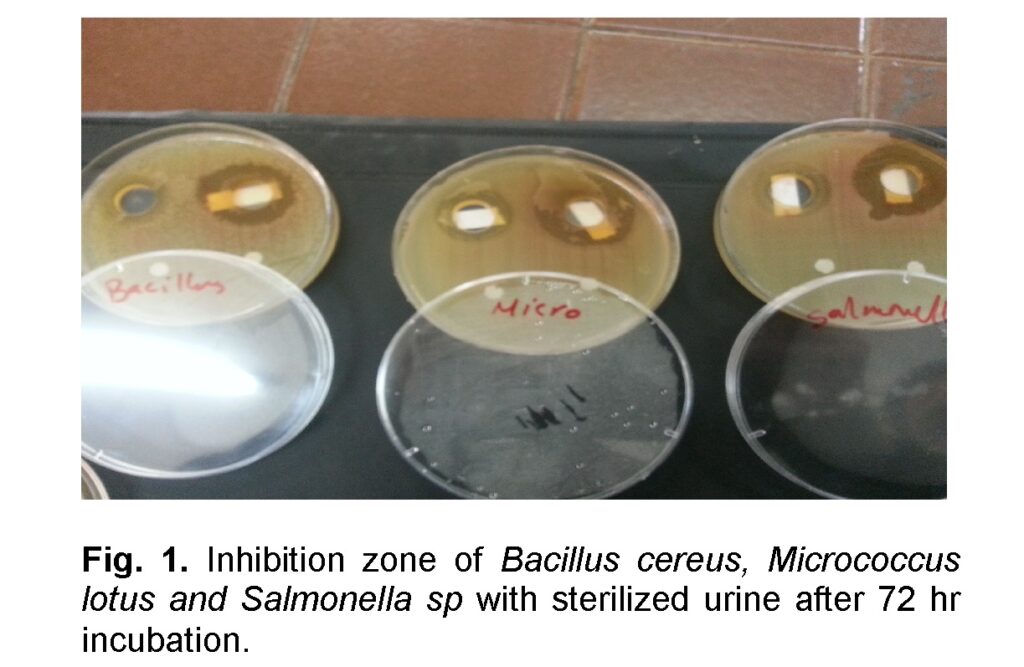
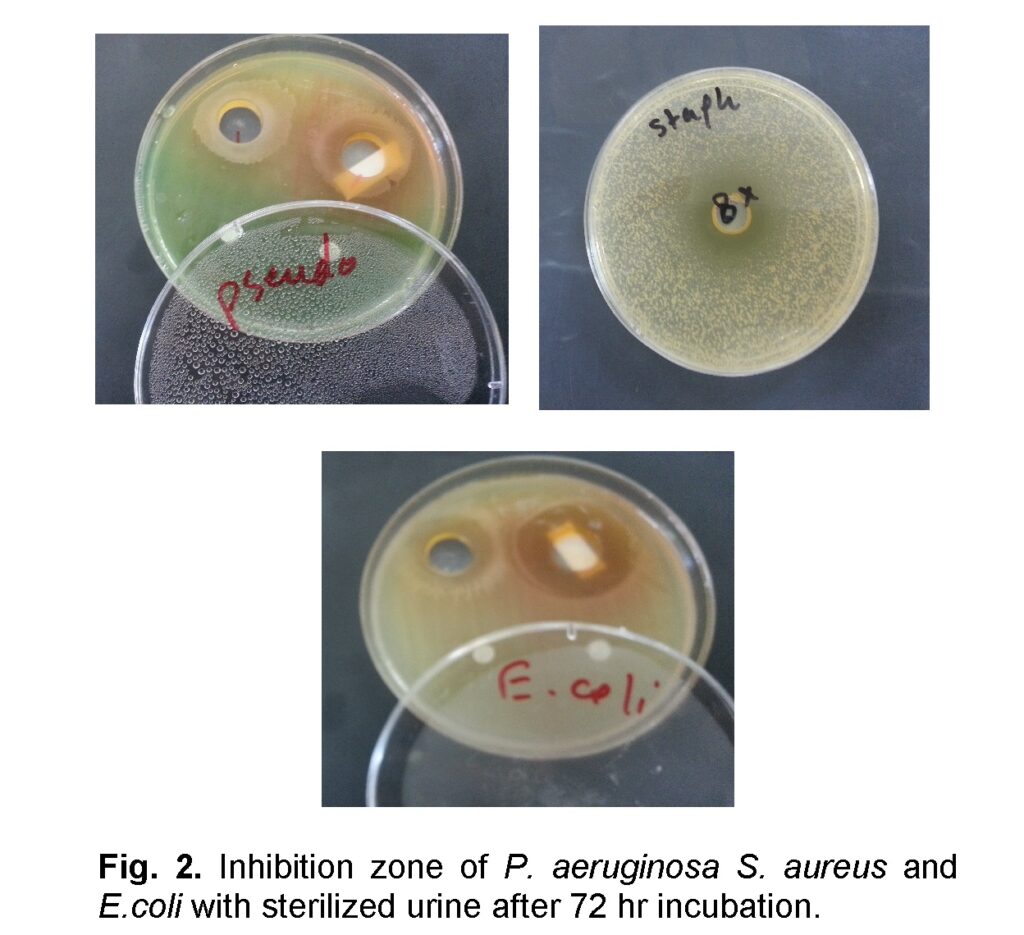

Antagonistic Effect of Camel’s Urine on Some Pathogenic Bacterial Species
Department of Biology, Faculty of Science, Sana’a University. Sana’a, Yemen.
*Corresponding author:
Abdelrahman A. Humaid;Email:
humaidyemen@yahoo.comViews 3855
Abstract
This work was designed to study antagonistic effect of camel’s urine on some pathogenic bacterial species. The best effect of camel’s urine was shown by camel’s sterilized urine followed by the heated urine while, the least effect was by the raw urine. The antibacterial activity of camel’s urine was very slightly and determinedly evident after 48 hours of incubation against Staphylococcus aureus, Micrococcus lotus, Bacillus cereus, Pseudomonas aeruginosa, Salmonella sp. and Escherichia coli. However, it was observed that the antibacterial activity of camel’s urine induced discriminatively marked inhibition zones of growth after 72h of incubation. The most microbes detected after 72h incubation were mainly Escherichia coli, Bacillus cereus, and Micrococcus lotus. It could be concluded that the camel’s urine have antimicrobial activities and resistance against the bacterial growth in the early stage of incubation, but the inhibitory effects of this urine on the bacterial growth were distinct after 72h of incubation.
Keywords
Camel’s urine, antagonistic effect, Staphylococcus aureus, Micrococcus lotus, Bacillus cereus, Pseudomonas aeruginosa, Salmonella sp, Escherichia coli.
Citation
Humaid, A.A., 2016. Antagonistic Effect of Camel’s Urine on Some Pathogenic Bacterial Species. PSM Vet. Res., 01(1): 08-12.
Introduction
According to a Hadith, peace and blessings be upon him, told Muslims to go out in the wake of camels and drink their urine in cure of illness (Al-Bukhari). In view of that, Muslims permitted by Islam to drink camels’ urine and milk for cure of illness. In Sunni Islam (the sahih Bukhari, the six major Hadith), it is quoted that Prophet Mohammed (P.B.U.H) advocating intake camel’s urine as a medication in more than a few verses (Hooper et al., 1998). There is nothing wrong in drinking the urine of camels in the cure of diseases, if it is prescribed by doctor who is consistent and honorable. Therefore, camel’s urine is allowed to drink in case of essential therapeutic handling. Due to its medical values, camel’s urine is used for the treatment of diseases it is described only by 35% and 63.33% of offenders in Babilie and Kebribeyah, in that order. According to these offenders camel’s urine is used for the treatment of scabies, ekek, yewefbshita and some other diseases (Mohamed, et al., 2004). Camel’s urine act as a slow – acting diuretic, it has a high level of potassium and proteins due to this reason it does not deplete potassium and other salts as other diuretics do.
It has also been effective against several kind of bacteria and viruses (Awhaaj, 1998; ALawadi and AL-Jedabi 2000) and have an inhibitory and antibiotic action in opposition to the growth of Candida albicans (yeast), Aspergillus niger, Fusarium oxysporum even after its boiling to 100°C. In addition, defenders of camel urine healing advise numerous ways through which the cure can slow or stop the development of cancer (Clark et al., 1988). One of these is urine can inspire the body’s immune system. Cancer and other diseases release antigens into the bloodstream, it responds by making antibodies to fight the invading disease in the bloodstream, when the immune system detects these antigens. Some of the antigens prepared by cancer cells come into view in the urine, so specialists have hypothesized that if they use urine to treat cancer patients, the immune system would react by manufacturing a larger number of antibodies, thus raising its capability to destroy tumor cells (Clark et al., 1988).
The antibacterial effect of the camel’s urine upon pathogenic bacteria that have been isolated and identified at the Military Hospital in Riyadh was studied, including the following bacteria: Acinetobacter spp, Enterococcus faecalis, Pseudomonas aeruginosa, Haemophilus influenzae, Klebsiella spp, Escherichia coli, Streptococcus pneumoniae, Citrobacter spp, Morganella morganii, Providencia spp, and Staphylococcus aureus (Shoeib and Ba-hatheq., 2007).
Al-Attas (2008), projected some fundamental elements inside milk and urine of camels by utilizing neutron activation analysis, and revealed that it consists of large number of Na and K substituting the failure of these elements in the case of diarrhea. Zn is also present in it in large amount which assists in the cure of the disease because of diarrhea. Eight different types of animal’s urine is used in medicine which are effective for the treatment of diseases. These can be classified into two main groups: Male; elephant, camel, horse, and ass. Female; cow, goat, sheep and buffalo. But camel urine is useful than all other animals according to specialists (Bellows, 2006).
Various diseases are prevalent across the globe (Abdel-Hamid et al., 2016; Toor et al., 2016; Ahsan et al., 2016; Iqbal et al., 2015; Iqbal et al., 2016; Muhammad et al., 2013) and different treatment measures have been used in the past. Urine, although a waste product of the body nonetheless has many medical applications and as such is used both internally and externally as medicine. The urines of animals such as goat, sheep, buffalo, elephant, horse, camel, donkey etc. were also very much in use as remedies for the treatment of worms, dropsy, abdominal enlargements, flatulence, colic, anaemia, abdominal tumor, loss of appetite, tuberculosis, poison, haemorrhoids, amenorrhea, leucoderma, leprosy, aggravation of kapha and vat and in many other mental diseases (Thakur, 2004). The risk factors associated with Hepatocellular carcinoma comprise age, sex, diet, alcohol, and hepatitis B virus (HBV) and/or hepatitis C virus (HCV) infection (Ali et al., 2015).
The present study was conducted to study the antibacterial effect of camel’s urine on some pathogenic bacterial species depending on the food of camels and environment.
Materials and Methods
Sample collection and preservation
Samples of camel’s urine were collected from male and female camels with ages from 6 months to 4 years fed on the different wild plants and forages at Sana’a, Hajja and Thamar Provinces. Samples were collected in sterile bottles and kept at 4°C for not more than 2 weeks.
Bacterial isolates
Six bacterial isolates were used in this investigation: Staphylococcus aureus, Bacillus cereus, Micrococcus lotus, Pseudomonas aeruginosa, Salmonella sp, Escherichia coli (Table 1). These isolates were collected from a laboratory in Microbiology Section Faculty of Science in Sana’s University.

Effect of urine on pathogenic bacteria
In vitro antimicrobial activity of urine was determined by the well diffusion method (Gul et al., 2004). The microbial isolates were spread over the surface of Mueller-hinton agar, blood agar and chocolate agar using sterile cotton swabs (Cheesbrouth, 1991). Wells were made on each plate by sterile cork borer (17mm diameter) and 0.2 ml of the urine was added to each well then the plates were kept in refrigerator for 1-2 hours before incubation. These plates were incubated at 37°C for 24,48,72 hr. Antimicrobial activity of urine (Raw-Heated-Sterilized) was detected as a result of clear inhibition zones around each well.
Results and Discussion
Antimicrobial effect of three types of camel urine (raw-sterilized and heated) was tested against gram negative and gram positive bacteria. The best effect of camel’s urine was shown by the camel’s sterilized urine followed by the heated urine while the least effect was the raw urine (Table 2,3,4).



Maximum antibacterial activity was observed against the mentioned bacteria after 72 h of incubation and manifested by a large diameter of inhibition zones, the organism having more inhibition zone were Escherichia coli, Bacillus cereus and Micrococcus lotus respectively whereas Pseudomonas aeruginosa, Salmonella sp. and Staphylococcus aureus have the least inhibition zone respectively (Figures 1, 2).

The antibacterial activity of camel urine is a very boundly and less obvious after 24-48 hours of incubation. Interpretation of this phenomenon in our opinion might be due to the involved microbes (as bacteriophages) of the bactericidal nature in the urine. The results of the present work are in agreement with those reported by Ahmed et al. (2002) and his colleagues which found that S. aureus, E.coli, Salmonella sp. and P. aeruginosa proved to be sensitive to camel urine. Our result in disagree with study done by AL-Bashan, (2011), who reported that regarding antibacterial activity of camel urine with 25, 50, 100% concentration, no growth inhibition zones were observed after 24 hours of incubation of all the culture media for the bacteria used.
The alkaline camel’s urine have boundly and strictly many antimicrobial activities and resistance against the bacterial growth in the early stage of incubation, but the inhibitory effects of this urine on the bacterial growth were distinct after 72 of incubation (AL-Bashan, 2011).
Amer and Al-hendi (1996) analyzed urine of mature camels, density ranged from 1.022 to 1.07 and pH values wide-ranging to be either acidic or alkaline. Urea level was within the range 18-36 gm/dL. Keratin was 0.2-0.5 gm/L. Presence of phosphorus and calcium oxalate and ammonium urate; some epithelial and granular cells proved by the microscopic analysis.
Camels urine contain certain factors such as antibiotics, salts and urea, also responsible for an immune system that is highly prepared to combat fungus, bacteria, viruses, due to antibodies which is present in it, the most advantageous urine is that of the Bedouin camels known as najeeb (Shinashal, 2014).
The results of heated camel’s urine in our study are in agreement with the results reported by Shoeib and Ba-hatheq, (2007) in Saudia Arabia; which showed that the heated camel’s urine had the best effect on the microbes. In our study the best effect against studied bacteria was of sterilized urine by autoclave followed by heated urine due to its high efficiency to overcome the bacterial cells.
Canavanine is excreted in camel urine of about 2% of the total urine content. According to literature, canavanine is a toxic antimetabolite of L-arginine and showed potent anti-neoplastic activity (Rosenthal et al., 2000; Vynnytska-Myronovska et al., 2012; Vynnytska et al., 2011). The use of camel urine as antibacterial, antifungal, antiparasitic and ingredient of cosmetics were reported by researchers (Christy et al., 2000; Natalie, 2002). The Na and K level in the camel urine is very high, because may be that camel survive in dry xerophytic condition to save the water and ionic balance in the body. The level of Mg in the camel urine is high. Mg is an important constituent of ATP and also plays an important role in the synthesis of DNA and RNA. It is also investigated as a cofactor in more than 300 enzymatic reactions which are required for the structural function of proteins, nucleic acids and mitochondria (Jahnen-Dechent and Ketteler, 2012).
These results showed that camel urine is effective against bacteria and can be used for the treatment of bacterial infections. Among natural remedies honey can be used as an alternative for treatment of various infections, especially those caused by antibiotic resistant bacteria (Iqbal et al. 2015).
Conclusion and Suggestions
Glory to Allah who grants therapy in His creatures. Glory to Allah who learns His Prophet Mohammad (peace and blessing of Allah be upon him) that there is an active medicine for bodies in camel’s urine. It could be concluded that the camels urine have many antimicrobial activities and resistance against the bacterial growth.
Acknowledgement
The authors are highly thankful to the institution for scientific research for technical support during this research work.
Conflict of Interest
The author confirms that this article content has no conflict of interest.
References
Abdel-Hamid, M., Ibrahim, Y.S., Ellakwa, D.E., Ahmed, S.N., 2016. Association of Serum Neopterin Level with HCV Infection among Egyptian Blood Donors. PSM Biol. Res., 01(1): 39-42.
Ahmed, M.E., Ahmed, A.E., Ahmed, H.E., 2008. Bacteria Associated with Healthy Sudanese Camels’ Urine and Drugs Susceptibility of Some Bacteria of Human Origin to Camel . Sudan J. Vet. Res., 23: 79- 82.
Ahsan, A., Iqbal, M.N., Ashraf, A., Yunus, F.N., Irfan, M., Saleem, M., 2016. Incidence of Pulmonary Tuberculosis among health care workers of Mayo Hospital, Lahore. PSM Biol. Res., 01(1): 26-30.
AL-Awadi, A., AL-Jedabi, A., 2000. Antimicrobial agents in camel’s Urine. (9B) Microbiol. Viruses. 8(11): 265-281.
Al-Attas, A.S., 2008. Determination of essential elements in milk and urine of camel and in Nigella sativa seeds. Arab. J. Chem., 1: 123-129.
AL-Bashan, M.M., 2011. In vitro assessment of the antimicrobial activity and biochemical properties of camel’s urine against some human pathogenic microbes. Middle East J. Sci. Res., 7(6): 947-958.
Ali, H.M., Bhatti, S., Iqbal, M.N., Ali, S., Ahmad, A., Irfan, M., Muhammad, A., 2015. Mutational analysis of MDM2 gene in hepatocellular carcinoma. Sci. Lett., 3(1):33-36.
Amer, H.A., Al-Hendi, A.B., 1996. Physical, biochemical and microscopical analysis of camel urine. J. Camel Pract. Res., 3(1):17-21.
Arora, D.R., Brij, B.A., 2012. Text book of microbiology Fourth edition, ISBN: 978-81-239-2190-7.
Awhaaj, M., 1998. Camel milk and urine hadiths. FEPS Lett., 93: 205-214.
Bellows, E., 2006. The effects of urea treatment in combination with curettage in extensive lip cancers. J. Surg. Oncol., 19: 127-131.
Cheesbrough, M., 1991. Medical Laboratory Manual for Tropical Countries, 1st ed. ELBS; 40-65, 228-254, 250-265.
Christy, M.M., 2000. Your own perfect medicine. Published by Wishland, Inc. Publishing P.O. Box 41504 Mesa, Arizona 85274.
Clark, P.I., Slevin, M.L., Webb, J.A., Osborne, R.J., Jones, S., Wringley, P.F., 1988. Oral urea in the treatment of secondary tumors in the liver. Br. J. Cancer., 57: 317-318.
Gul, N., Mujahik, T.Y., Jehan, N., Ahmed, S., 2004. Studies on the antibacterial effect of different fraction of Curcuma longa against urinary tract infection isolates. Pak. J. Biol. Sci., 7(12): 2055-2060.
Hooper, D.C., 1998. Expanding uses of Fluor quinolones: Opportunities and Challenges. Ann. Intern. Med., 129(11): 908-910.
Iqbal, M.N., Anjum, A.A., Ali, M.A., Hussain, F., ALI, S., Muhammad, A., Irfan, M., Ahmad, A., Irfan, M. and Shabbir, A., 2015. Assessment of microbial load of un-pasteurized fruit juices and in vitro antibacterial potential of honey against bacterial isolates. Open Microbiol. J., 9: 26-32. DOI: 10.2174/1874285820150601E001.
Iqbal, M.N., Akhter, S., Irfan, M., 2015. Prevalence of hernia in relation to various risk factors in Narowal, Pakistan. Sci Lett., 3(1):29-32.
Iqbal, M.N., Ashraf, A., Yunus, F.N., Muhammad, A., Alam, S., Xioa, S., Ali, S., Irfan, M., 2016. Prevalence of Angina Pectoris in relation to various risk factors. PSM Biol. Res., 01(1): 06-10.
Jahnen-Dechent, W., Ketteler, M., 2012. Magnesium basics. Clin. Kidney J., 5(Supp1.1): i3-i14.
Mohamed, M., Hooper, T.L., Rahman, M., Magell, J., 2004. Urotherapy for patients with cancer. Med Hypotheses, 48:309-315.
Muhammad, A., Farooq, M.U., Iqbal, M.N., Ali, S., Ahmad, A., Irfan, M., 2013. Prevalence of diabetes mellitus type II in patients with hepatitis C and association with other risk factors. Punjab Univ. J. Zool., 28 (2): 69-75.
Natalie, B., 2002, Urine therapy (drinking urine ). J Berkley Med.
Rosenthal, G., Nkomo, P., 2000. The natural abundance of L-canavanine, an active anticancer agent ,in alfalfa, Medicago sative (L.). Pharm. Biol., 38(1):1-6.
Sahih Al-Bukhari. Collection of Authentic Hadith by Muhammad al-Bukhari (810-870 A.D).
Shinashal. R.Z., 2014. The capability of camels urine in the treatment of infection caused by Escherichia coli and Staphylococcus aureus. J. College Edu. Pure Sci., 4(1): 335-341.
Shoeib, A., Ba-hatheq, A., 2007. Effect of camel’s Urine on pathogenic P.aeruginosa and E.coli Isolates towards its Maintains to their Antibiotic(s) Resistance and the presence of Plasmid(S). Saudi J. Biol. Sci., 14(2):177-184.
Thakur, A.N., 2004. Therapeutic use of urine in early Indian medicine. Indian J. History Sci., 39(4): 415-427.
Toor, S., Toor, S., Ashraf, A., Alam, S., Anwaar, S., Saddiqa, A., Ali, S., Muhammad, A., Toor, S., Akhter, S., 2016. Prevalence of Liver disorders in Islamabad City. PSM Biol. Res., 01(1): 31-33.
Vynnytska-Myronovska, B., Bobak, Y., Garbe, Y., Dittfeld, C., Stasyk, O., Kunz-Schughart, L.A., 2012. Single amino acid arginine starvation efficiently sensitizes cancer cells to canavanine treatment and irradiation. Int. J. Cancer, 130 (9): 2164-2175.
Vynnytska, B.O., Mayevska , O.M., Kurlishchuk, Y.V., Boak, Y.P., Stasyk, O.V., 2011. Canavanine augments proapoptotic effects of arginine deprivation in cultured human cancer cells. Anticancer Drugs, 22(2): 148-157.
